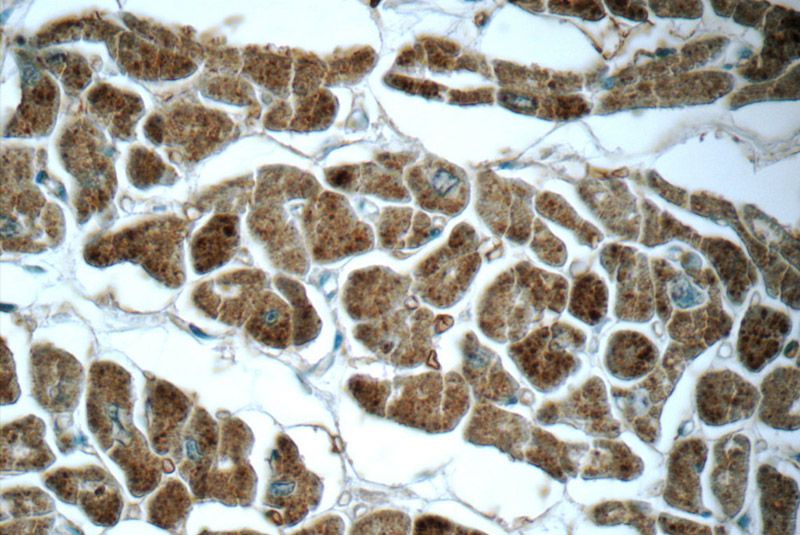
Immunohistochemistry of paraffin-embedded human heart tissue slide using Catalog No:111251(GUCY2F Antibody) at dilution of 1:50 (under 40x lens)

-
Product Name
GUCY2F antibody
- Documents
-
Description
GUCY2F Rabbit Polyclonal antibody. Positive WB detected in mouse heart tissue. Positive IHC detected in human heart tissue. Observed molecular weight by Western-blot: 125 kDa
-
Tested applications
ELISA, WB, IHC
-
Species reactivity
Human, Mouse; other species not tested.
-
Alternative names
CYGF antibody; GC F antibody; guanylate cyclase 2F antibody; retinal antibody; Guanylate cyclase F antibody; GUC2DL antibody; GUC2F antibody; GUCY2F antibody; RETGC 2 antibody; RETGC2 antibody; Retinal guanylyl cyclase 2 antibody; ROS GC2 antibody
-
Isotype
Rabbit IgG
-
Preparation
This antibody was obtained by immunization of GUCY2F recombinant protein (Accession Number: NM_001522). Purification method: Antigen affinity purified.
-
Clonality
Polyclonal
-
Formulation
PBS with 0.1% sodium azide and 50% glycerol pH 7.3.
-
Storage instructions
Store at -20℃. DO NOT ALIQUOT
-
Applications
Recommended Dilution:
WB: 1:200-1:2000
IHC: 1:20-1:200
-
Validations

mouse heart tissue were subjected to SDS PAGE followed by western blot with Catalog No:111251(GUCY2F Antibody) at dilution of 1:600

Immunohistochemistry of paraffin-embedded human heart tissue slide using Catalog No:111251(GUCY2F Antibody) at dilution of 1:50 (under 10x lens)
Immunohistochemistry of paraffin-embedded human heart tissue slide using Catalog No:111251(GUCY2F Antibody) at dilution of 1:50 (under 40x lens)
-
Background
GUCY2F(Guanylate cyclase 2F, retinal) is also named as GUC2F, RETGC2 and belongs to the adenylyl cyclase class-4/guanylyl cyclase family. GUCY2F may play a specific functional role in the rods and/or cones of photoreceptors. It may be the enzyme involved in the resynthesis of cGMP required for recovery of the dark state after phototransduction. By in situ hybridization, mRNA encoding GUCY2F is found only in the outer nuclear layer and inner segments of photoreceptor cells. By using synthetic peptide antiserum specific for each RetGC subtype, RetGC-2(GUCY2F) can be distinguished from RetGC-1 as a slightly smaller protein in immunoblots of bovine rod outer segments.(PMID:7777544).
Related Products / Services
Please note: All products are "FOR RESEARCH USE ONLY AND ARE NOT INTENDED FOR DIAGNOSTIC OR THERAPEUTIC USE"
